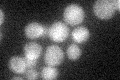
YGL154C
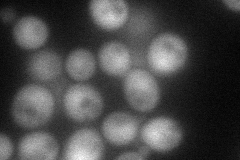
YGL154C
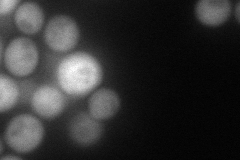
YGL154C
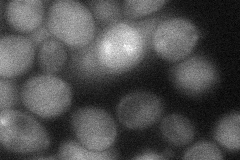
YGL154C
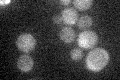
YGL154C

View description
Phosphopantetheinyl transferase involved in lysine biosynthesis; converts inactive apo-form of Lys2p (alpha-aminoadipate reductase) into catalytically active holo-form by posttranslational addition of phosphopantetheine
Localization:
Intensity:
Fold change:
Significance:
-
C’ GFP library in SD
cytosol20.01 -
N' NOP1pr-GFP in SD
cytosol74.3315 -
N' TEF2pr-mCherry in SD
cytosol81.3259 -
N' NATIVEpr-GFP in SD

below threshold18.6457 -
N' TEF2pr-VC and Cyto-VN in SD
cytosol38.6962 -
C’ GFP library in SD+DTT

cytosol20.411.01No -
C’ GFP library in SD+H2O2

cytosol18.230.91No -
C’ GFP library in Starvation Media
cytosol18.370.91No -
C’ GFP library on the background of Pup2-DaMP

cytosol -
C’ GFP library on the background of CCT mutant

cytosol18.75280.936636No
